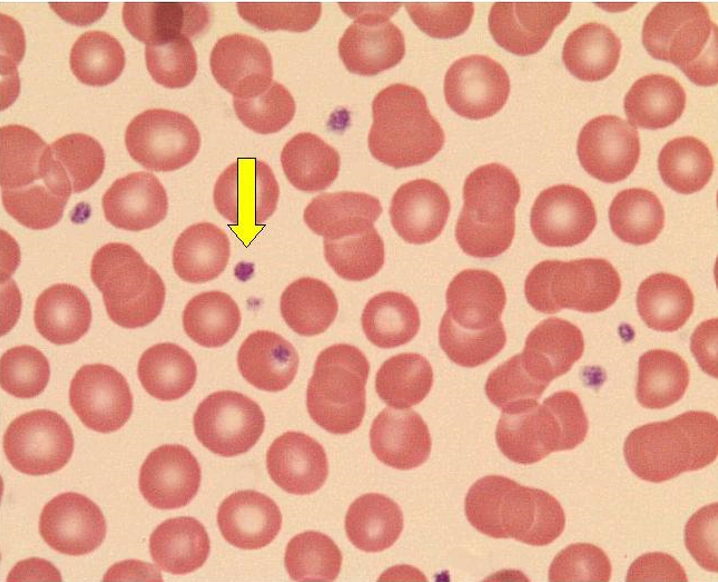
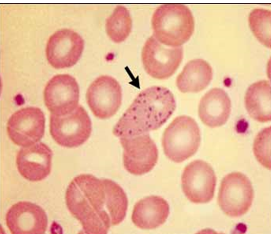
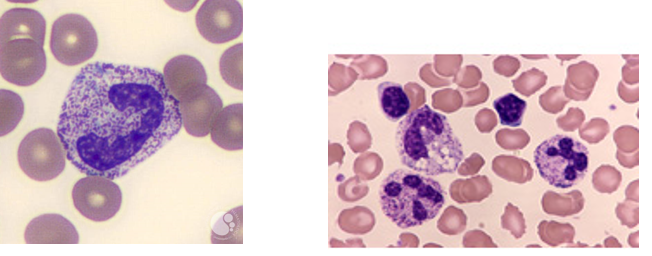
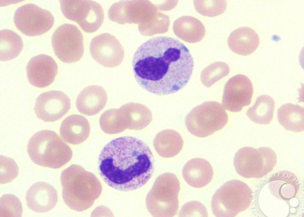
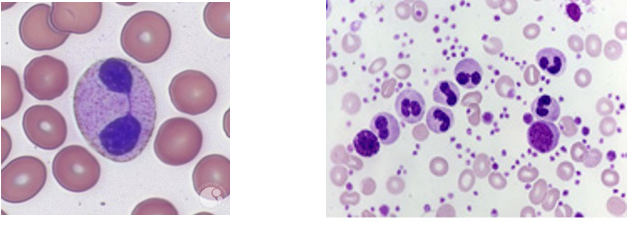
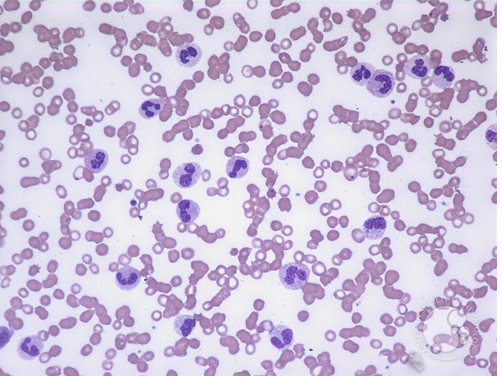
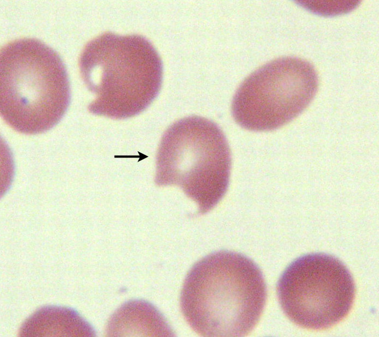
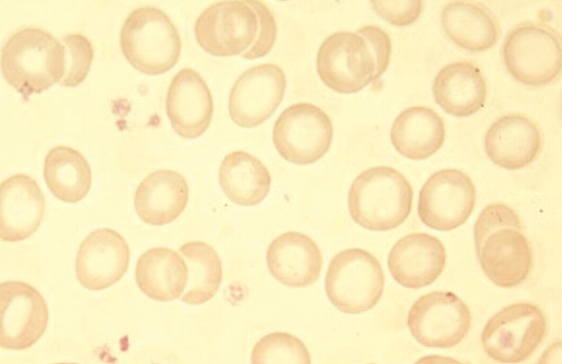
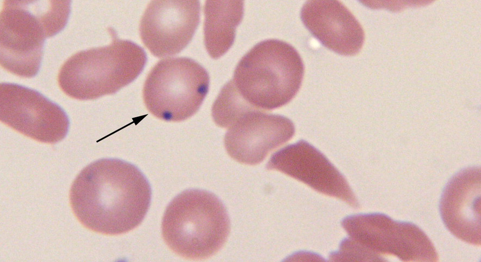
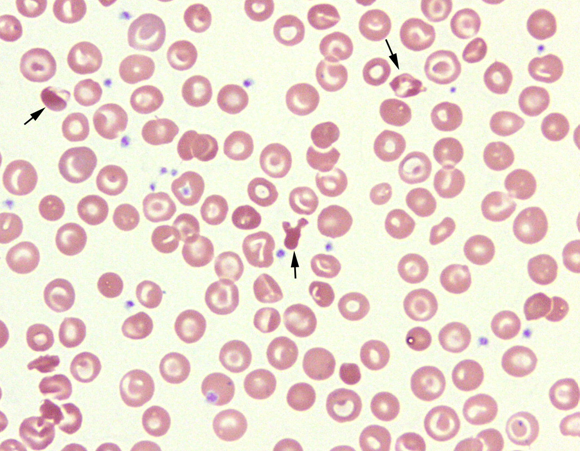
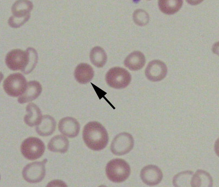
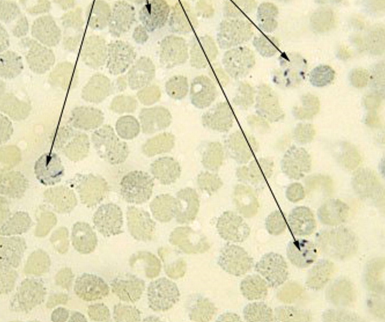
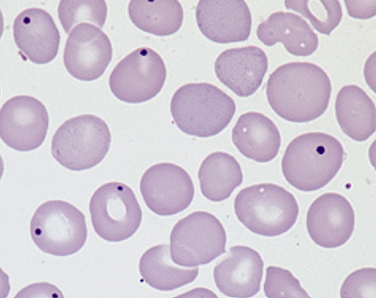
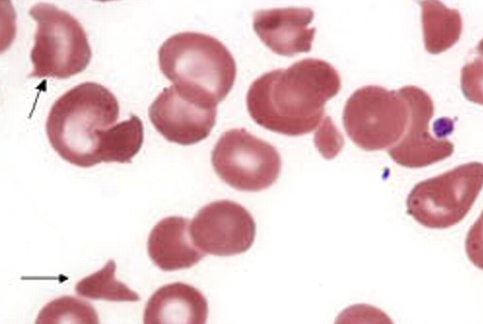
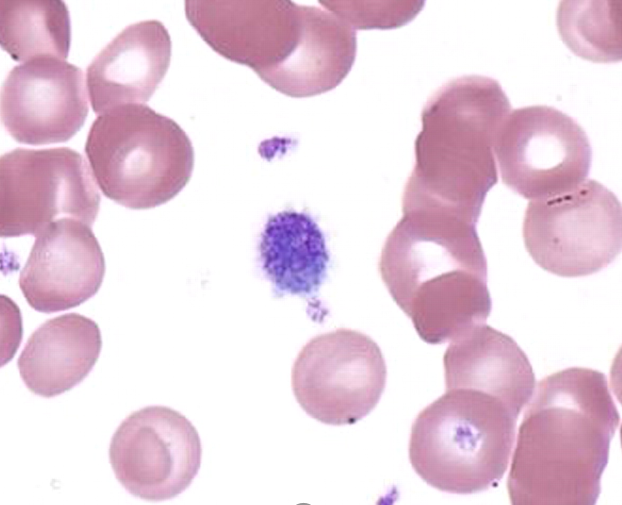

myeloblast

band neutrophils

megakaryocytes
platelets

aplastic anemia- look at the big fat gaps
lead Pb toxicity

nuclear-cytoplasmic dyssynchrony as seen in megaloblastic anemia
toxic granulation.
Dohle bodies as seen in may hegglin anomaly
Pelger-Huet as seen in MDS

left shift in WBC- increase in immature granulocytic forms
leukemoid reaction- marked leukocytosis with immature granulocytes

Bite cells as seen in G6PD

Heinz bodies-G6PD deficiency
Bite cell- see in G6PD due to the removal of Heinz bodies bodies by macrophages in the spleen
iron deficiency- note the profound central pallor of the hypochromic and microcytic RBC
Howell-jolly bodies- seen in sickle cell anemia with a functional hyposplenia
Peripheral smear from a patient with SC disease is shown. Note the presence of target cells, polychromatophilic
spherocyte- small spherical cells without central pallor as seein in thalassemia
The blue stained inclusions in the RBC are oxidatively denatured precipitates of HbH
Howell-Jolly bodies are red cell inclusions that are residual nuclear fragments. They may be seen in hemolysis, megaloblastic anemia, or post-splenectomy.
Peripheral smear showing RBC fragmentation consistent with a microangiopathic hemolytic process

Heinz bodies as seen in G6PD
Giant platelet circulating in the peripheral blood of a patient with a myeloproliferative disorder

























